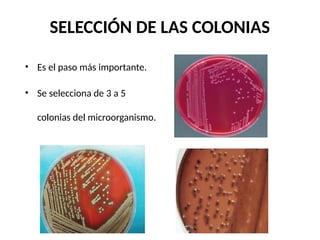
SELECCIÓN DE LAS COLONIAS
• Es el paso más importante.
• Se selecciona de 3 a 5
colonias del microorganismo.
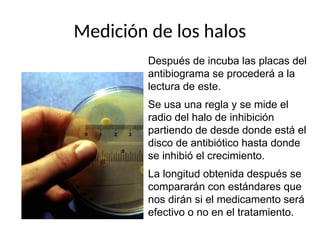
Medición de los halos
Después de incuba las placas del
antibiograma se procederá a la
lectura de este.
Se usa una regla y se mide el
radio del halo de inhibición
partiendo de desde donde está el
disco de antibiótico hasta donde
se inhibió el crecimiento.
La longitud obtenida después se
compararán con estándares que
nos dirán si el medicamento será
efectivo o no en el tratamiento.

El antibiograma es un método in vitro que determina la susceptibilidad de microorganismos a agentes antimicrobianos, utilizando conceptos como la concentración mínima inhibitoria (CIM) y la concentración bactericida mínima (CBM). Los métodos empleados incluyen la dilución y la difusión en agar, siendo este último el más común en laboratorios. Los antibióticos se clasifican en varias categorías, y el proceso de antibiograma implica seleccionar colonias de microorganismos, estandarizar el inóculo y medir la inhibición del crecimiento en función de la eficacia de los antibióticos.